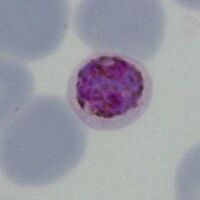

Biology of the gametocyte
From haematologyetc.co.uk
Navigation
>Main Malaria Index
>>Malaria Biology Index
>>>Gametocyte Biology
Biology of the Gametocyte
|
The sexual form of the malarial parasite has either male or female form (a higher percentage are female). Generally male gametocytes (microgametocytes) are smaller then the female form (macrogametocytes). They are effectively “dormant” in blood and only develop further when ingested by a mosquito (the temperature drop in the mosquito foregut rapidly activates them to a single female gamete or 8 male gametes (see section on re-infection of the mosquito).
Gametocytes (like schizonts) are the final mature form of parasites in the blood, consequently they have metabolised all haemoglobin in order to grow. The red cell is therefore now simply a membrane that surrounds the parasite without any red colour, and with prominent malaria pigment that represents the metabolised haem iron. The appearance of gametocytes however does vary according to species and this can aid morphological species identification P.malariae Like other stages in this species the red cell containing the parasite is not enlarged or distorted and may be small. Parasites are typically small and neat with rounded form that do not fill the red cell. P.vivax Typically these are very enlarged (significantly larger than normal red cells) often retaining the irregular shape that is typical of P.vivax trophozoites
(5) P.knowlesi – typically sightly enlarged and may be fimbriated → Click for the clinical gametocyte gallery
|